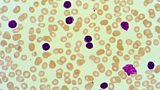

FM Schedule
Early
00:00
Midnight News—07/06/2013
The latest national and international news from BBC Radio 4.
00:30
Book of the Week—Damian Barr - Maggie and Me, Episode 4
4/5Damian is caught up in a secret school visit from Scottish poll tax protesters.(R)
00:48
Shipping Forecast—07/06/2013
The latest shipping forecast.
01:00
Selection of BBC World Service Programmes—07/06/2013
BBC Radio 4 joins the BBC World Service.
05:20
Shipping Forecast—07/06/2013
The latest shipping forecast.
05:30
News Briefing—07/06/2013
News from BBC Radio 4.
05:43
Prayer for the Day—07/06/2013
A spiritual comment and prayer to begin the day with Canon Stephen Shipley.
05:45
Farming Today—07/06/2013
Threats of an impending crisis to Britain's landscape as EU subsidies change.
05:58
Tweet of the Day—Goldfinch
Miranda Krestovnikoff presents the story and sound of the goldfinch.
- Back to top
Morning
06:00
Today—07/06/2013
Including Yesterday in Parliament, Sports Desk and Thought for the Day.
09:00
Desert Island Discs—Sir Mervyn King
Sir Mervyn King, outgoing governor of the Bank of England, is interviewed by Kirsty Young.
09:45
Book of the Week—Damian Barr - Maggie and Me, Episode 5
5/5Damian escapes to university and fulfils his dream of becoming a journalist.
10:00
Woman's Hour—Women and birdwatching; Why are Turkish women demonstrating?
The women who began the RSPB. Turkish women protest for their rights. With Jenni Murray.
10:45
15 Minute Drama—Kidnap, Resolution
5/5Lucy awaits her mother's release from captivity, with ambiguous feelings about her return.
11:00
New Broadcasting House
Sian Williams, Jim Naughtie and guests consider the cultural identity of a London landmark
11:45
Four Thought—Series 4, Anna Woodhouse: Windows to the Soul
9/3Anna Woodhouse explores what looking through glass and glasses means for us.(R)
- Back to top
Afternoon
12:00
You and Yours—Disabled sport, infested houses, soap star diets
Peter White asks why young people with disabilities are struggling to get into sport.
12:52
The Listening Project—Linda and Ruona - Circumcision
Two friends from Nigeria talk about what it means to marry white men and live in the UK.
12:57
Weather—07/06/2013
The latest weather forecast.
13:00
World at One—07/06/2013
National and international news.
13:45
Disability: A New History—A Disabled Identity
10/10Peter White reveals the roots of a modern disabled identity in the 19th century.
14:00
The Archers—06/06/2013
Emma has a good idea.
14:15
Drama on 4—The No. 1 Ladies' Detective Agency, The Seller of Beds
2/2The detectives are embroiled in the murky world of the football cheat.(R)
15:00
Gardeners' Question Time—Stoke-on-Trent
Eric Robson chairs the horticultural panel programme in Stoke-on-Trent.
15:45
Four Bare Legs in a Bed—An Interesting Condition
2/3Fear and loathing in an antenatal class. Read by Rosie Cavaliero.
16:00
Last Word—A novelist, a botanist, a TV writer, a missionary and a composer
Mark Coles on Tom Sharpe, Nigel Hepper, Anne Valery, Henri Dutilleux, Molly Clutton-Brock.
16:30
More or Less—A&E, and the chances of having twins
Tim Harford explores the world of official statistics, plus the chances of having twins.
16:55
The Listening Project—Helen and Tom - Now You're Home
A mother and son talk about why he disappeared in Thailand and how she coped.
17:00
PM—07/06/2013
Interviews, context and analysis.
- Back to top
Evening
18:00
Six O'Clock News—07/06/2013
National and international news from BBC Radio 4.
18:30
The Now Show—Series 40, Episode 4
4/6Steve Punt and Hugh Dennis join Holly Walsh, John Finnemore, Laura Shavin and Mitch Benn.
19:00
The Archers—07/06/2013
Peggy manages to sort things out.
19:15
Front Row—Marc Chagall, Laura Marling, Frank Cottrell Boyce, Colm Tóibín
Marc Chagall, Laura Marling, Frank Cottrell Boyce and Colm Tóibín's Cultural Exchange.
19:45
15 Minute Drama—Kidnap, Resolution
5/5Lucy awaits her mother's release from captivity, with ambiguous feelings about her return.
20:00
Any Questions?—Owen Paterson, Peter Hain, Leanne Wood, James Delingpole
Jonathan Dimbleby presents political debate and discussion from Machynlleth, Wales.
20:50
A Point of View—Can Compassion Be Taught?
Tom Shakespeare asks if compassion can be taught, in the first of his four essays.
21:00
Disability: A New History—Omnibus Edition - 2/2
12/10Peter White reveals the lives of physically disabled people in the 18th and 19th centuries
21:58
Weather—07/06/2013
Weather information.
22:00
The World Tonight—07/06/2013
GCHQ accused of secretly gathering info from covert US operation. With Philippa Thomas.
22:45
Book at Bedtime—Sarah Dunant - Blood and Beauty, Episode 10
10/10Juan's arrogance causes mayhem, and Cesare tries to comfort his sister.
23:00
A Good Read—Terry Deary and Shappi Khorsandi
Terry Deary of Horrible Histories and Shappi Khorsandi talk books with Harriett Gilbert.(R)
23:30
Today in Parliament—07/06/2013
Mark D'Arcy reports from Westminster.
23:55
The Listening Project—Craig and Luke - No Laughing Matter
It's not funny being a comedian. It's frightening. Craig and Luke feel the fear.
- Back to top
Late
00:00
Midnight News—08/06/2013
The latest national and international news from BBC Radio 4.
00:30
Book of the Week—Damian Barr - Maggie and Me, Episode 5
5/5Damian escapes to university and fulfils his dream of becoming a journalist.(R)
00:48
Shipping Forecast—08/06/2013
The latest shipping forecast.
01:00
Selection of BBC World Service Programmes—08/06/2013
BBC Radio 4 joins the BBC World Service.
05:20
Shipping Forecast—08/06/2013
The latest shipping forecast.
05:30
News Briefing—08/06/2013
The latest news from BBC Radio 4.
05:43
Prayer for the Day—08/06/2013
Spiritual comment and prayer with Perthshire minister, the Rev Marjory MacLean.
05:45
iPM—08/06/2013
Why is there no UK town called 'Hedgehog'? A listener calls for MPs to take action.